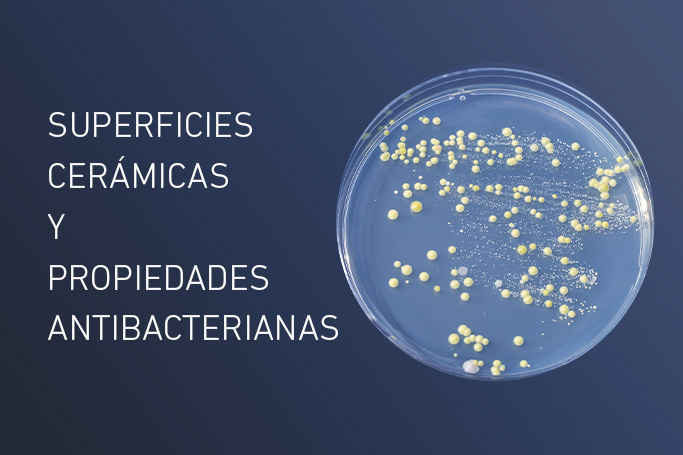

Cerámica
Cerámica
11.03.21 |
Se acerca el calor y los productores de cerámica se empiezan a preocupar por un problema al que deben enfrentarse todos los años: ¿cómo evitar los organismos nocivos, que proliferan con el calor...
17.12.20 |
En los últimos años hemos visto cómo la granilla se convertía en la protagonista de los materiales cerámicos para decoración. Lejos de perder interés, desde el sector no dejamos de innovar con tal...
El jueves 3 de diciembre se llevó a cabo el quinto webinar de la Z&S School, el último de 2020. Con el título “Innovación transversal en la industria química”, el Dr. José Planelles, de...
Hace más de 30 años, los primeros sistemas de impresión digital cerámica ya estaban disponibles para su uso en la industria de las artes gráficas. En el sector cerámico, el primer sistema inkjet...
El contexto actual Los materiales antibacterianos han sido durante mucho tiempo un tema de gran interés en la industria cerámica, pero por razones obvias se ha convertido ahora en un área de investigación...
03.09.20 |
Zschimmer & Schwarz y Nanoprom combinan su experiencia ofreciendo un nuevo y atractivo campo en el sector de los tratamientos para superficies cerámicas. Zschimmer & Schwarz, en concordancia con una perspectiva que enfatiza...
14.08.20 |
Como ya sabemos, los azulejos, ya sean para suelo o revestimiento de paredes, vienen condicionados por importantes aspectos técnicos y estéticos que hacen de ellos un producto único, difícil de comparar a otra...
20.02.20 |
Cuando hablamos de retos en la industria cerámica, las palabras eficiencia y sostenibilidad no tardan en aparecer. Al fin y al cabo, tradicionalmente el proceso de producción en el sector ha consumido grandes...
12.02.20 |
Tras una intensa semana en la feria de la cerámica, es momento de hacer balance y concluir qué ha supuesto esta 38ª edición de Cevisama para nuestra compañía. El tiempo y el esfuerzo...
08.11.19 |
Nuestro director general Carlos Vivas impartió ayer una ponencia durante el Congreso Internacional del Técnico Cerámico, celebrado los días 7 y 8 de noviembre en las instalaciones de la Fundación Universitat Jaume I-Empresa...

NEWSLETTER
MANTENTE AL DÍA
Suscríbete a nuestro newsletter y te informaremos sobre novedades y productos destacados.
No hemos podido validar su suscripción.
Se ha realizado su suscripción.